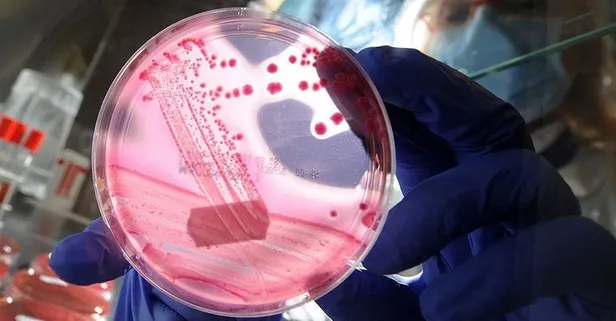
Pankreasa iyi gelenler kırmızı

Pankreasa iyi gelenler kırmızı
Prof. Dr. Metin Kement, pankreas kanserinin erken belirtilerine dikkat çekerek, sigaradan uzak durulması ve kırmızı meyvelerle beslenilmesi gerektiğini vurguluyor.
Giriş Tarihi:
Pankreas kanseri, adıyla bile korkutmaya yetiyor. Prof. Dr. Metin Kement, organlara yayıldığını vurguluyor. Kanserin belirtilerinin sırta vuran karın ağrısı, diyabet, gözlerde sararma ve hızlı kilo kaybı olduğunu söylüyor. Bu hastalıktan korunmanın yollarını açıklıyor: Sigara içilmemeli. Antioksidan açısından zengin olan kırmızı üzüm, çilek, ahududu gibi kırmızı meyveler tüketilmeli
